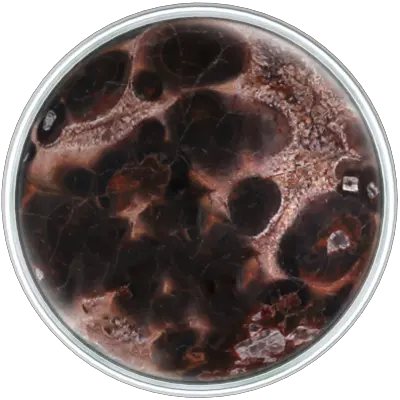

Leopard Skin Jasper Natural Stone Upholstery Nail
Embrace the Spirit of Adventure with Leopard Skin Jasper
Step into a world where time is a mere backdrop and the allure of adventure beckons. Leopard Skin Jasper, with its throwback patterning, transports you to an era of exploration and charm, offering an experience that's both bold and breathtakingly gorgeous.
But Leopard Skin Jasper is more than just a relic of the past; it's a catalyst for the present and the future. As you embrace its distinctive pattern, a surge of creativity and visualization is ignited, transforming your surroundings into a canvas of endless possibilities.
Picture the thrill of being in a room adorned with Leopard Skin Jasper, where quick thinking becomes second nature and your imagination is a boundless playground. Imagine the effect of its energies, how it enhances not just the aesthetic, but the very essence of the space it inhabits.
Leopard Skin Jasper isn't just a stone; it's a companion on your journey of self-discovery and ingenuity. It's a testament to the power of nature to stimulate the mind and uplift the spirit. As you integrate it into your personal spaces, you're not just adding an element of design; you're infusing your environment with a touch of the extraordinary.
Delve into the beauty of Leopard Skin Jasper – a gem that transcends time and style. Let it be a mirror to your sense of adventure, your longing for exploration, and your desire to be immersed in the marvels of the world. With each piece being a unique testament of nature's artistry, boasting patterns and colors that vary dramatically, you're embracing not just a stone, but a story waiting to unfold.
Choose Leopard Skin Jasper not just as an adornment, but as a manifestation of your thirst for adventure, creativity, and the exquisite beauty of the natural world. Embrace the allure, the uniqueness, and the transformative energies of Leopard Skin Jasper as you embark on a journey of exploration and self-expression.